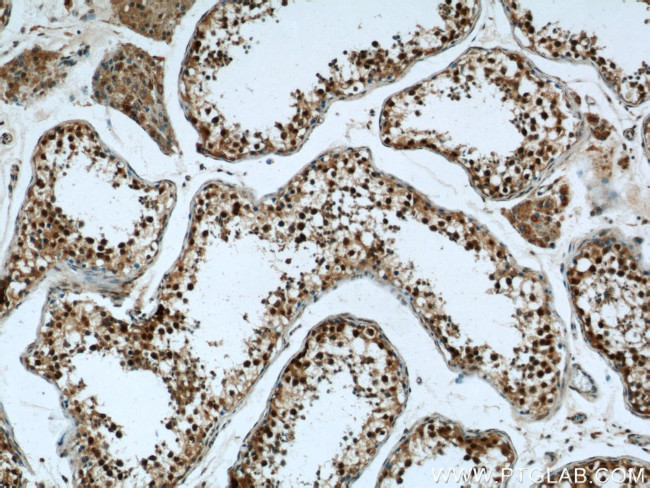
CRCP Antibody in Immunohistochemistry (Paraffin) (IHC (P))
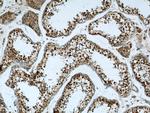
CRCP Antibody in Immunohistochemistry (Paraffin) (IHC (P))

Search
Proteintech
CRCP Polyclonal Antibody
{{$productOrderCtrl.translations['antibody.pdp.commerceCard.promotion.promotions']}}
{{$productOrderCtrl.translations['antibody.pdp.commerceCard.promotion.viewpromo']}}
{{$productOrderCtrl.translations['antibody.pdp.commerceCard.promotion.promocode']}}: {{promo.promoCode}} {{promo.promoTitle}} {{promo.promoDescription}}. {{$productOrderCtrl.translations['antibody.pdp.commerceCard.promotion.learnmore']}}
产品信息
14348-1-AP
种属反应
宿主/亚型
分类
类型
抗原
偶联物
形式
浓度
规格
纯化类型
保存液
内含物
保存条件
运输条件
产品详细信息
Immunogen sequence: MEVKDANSA LLSNYETLKY ISKTPCRHQS PEIVREFLTA LKSHKLTKAE KLQLLNHRPV TAVEIQLMVE ESEERLTEEQ IEALLHTVTS ILPAEPEAEQ KKNTNSNVAM DEEDPA (1-115 aa encoded by B C040107)
靶标信息
This gene encodes a membrane protein that functions as part of a receptor complex for a small neuropeptide that increases intracellular cAMP levels. Alternate transcriptional splice variants, encoding different isoforms, have been characterized.
仅用于科研。不用于诊断过程。未经明确授权不得转售。
生物信息学
蛋白别名: Calcitonin gene-related peptide-receptor component protein; CGRP-RCP; CGRP-receptor component protein; CGRPRCP; DNA-directed RNA polymerase III subunit RPC9; RNA polymerase III subunit C9; unnamed protein product
基因别名: AL022669; C17; CGRP-RCP; CGRPRCP; CRCP; POLR3I; POLR3J; RCP; RCP9; RPC9
UniProt ID: (Human) O75575, (Mouse) O35427, (Rat) Q8VHM6
Entrez Gene ID: (Human) 27297, (Mouse) 12909, (Rat) 114205